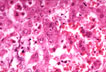

HERPES GROUP
CYTOMEGALOVIRUS (CMV) HEPATITIS
The infection with this virus is very common but, in healthy people does not produce disease. It may be, however, pathogenic in newborns and in immunocompromised hosts. Approximately 50% of adults are infected with CMV. Perinatal infection can be contracted in utero, from infected maternal genitalia and from breast milk. Only Less than 5% of infected newborns develop symptoms. Practically all pirmary infections are asymptomatic but the infected individuals excrete the virus in the urine and saliva for months and years and are infectious. The virus may be reactivated from the latent state by decreased imune response usually induced by disease or drugs especially by immunosuppressant therapy where reactivation of a primary infection and not re-infection appears to be the norm. The white cells of 5% of blood donors contain CMV virus therefore infection by blood transfusion occurs in a large number (60%?) of patients. Because of the wide distribution and the asymptomatic occurrence of CMV infection it is crucial to test donors for organ transplantation. An infected organ under immunosuppressive therapy will reactivate the virus with disastrous consequences.
The virus
Is a member of the herpesviridae family together with herpes simplex, Epstein-Barr, varicella-zoster viruses. The viral particles consist of a DNA core, a icosahedral capsid, adn a surrounding envelop. Under electron microscopy there are herpes-like virions, defective viral particles and spherical particles called dense bodies. Infected cell may become cytomegalic but since the infection may not produce morphological changes, the absence of large cells and of intranuclear inclusions do not exclude the infection.
Clinical features
Healthy individuals. The infection is usually symptomless and produces IgG antibodies.
Neonatal period. The infection acquired in the may present a serious illness which begins shortly after birth with jaundice, purpura, hemolytic anemia, thrmobocytopenia, brain damage, microcephaly and paravetricular calcifications. The liver presents cholestasis, fatty changes, focal necrosis with cytomegalic cells in hepatocytes and bile ducts. Fatality is high but some patients may recover completely or may come out with permanent brain damage.
Early childhood. The infection may produce a chronic disease with abnormal liver function tests and recurrent fever and jaundice. CMV antibodies are rising.
Adulthood. The infection is usually asymptomatic. Some adults and older children may develop "glandular fever", the so-called Cytomegalic Mononucleosis consisting of a febrile illness of 3-6 weeks duration with lymphocytosis, abnormal lymphocytes but negative Paul-Bunnell test and absence of sore throat and lymphadenitis. The liver may reveal changes compatible with viral hepatitis. Cytomegalic cells are not present. Similar symptoms may appear in the so-called Postperfusion Syndrome which develops after massive transfusions from multiple donors in both positive and negative individuals for anti-CMV antibodies.
Pregnant women also are asymptomatic at primary infection but they may infect the fetuses.
Immunosuppressed patients. The reactivated infection may produce a systemic disease with fatal pneumonitis and/or liver failure.
Pathology
Presence of "cytomegalic" cells with reddish-blue intranuclear inclusions surrounded by a clear halo to impart a peculiar owl's eye appearance, hepatocytes, bile duct epithelium, endothelial and connective tissue cells.
In cases of congenital hepatitis the picture is that of a severe "neonatal hepatitis" with necrosis and formation of multinucleated giant cell without significant inflammatory cell reaction. Other organs are also serverly involved.
In cases of cytomegalovirus mononucleosis, which are rare, the liver shows a prominent diffuse lobular inflammation with lymphocytes, plasma cells and macrophages without significant necrosis. There is also portal inflammation with same cells. Cytomegalic cells and viral inclusion bodies are usually absent. The picture is similar to that of infectious mononucleosis and can be confused with acute viral hepatitis.
Diagnosis (By Dr. Enric Solans)
The "gold standard" for diagnosis of CMV is the conventional cell culture based on the appearance of the typical cytopathic effect (CPE) in the infected cells. However, an average of 7-10 days is required for the CPA to develop, which in a critically ill patient is too long. A more rapid diagnosis (24 to 48 h) is possible by using the shell vial assay. This assay requires the incubation of the sample submitted with a monoclonal antibody, labeled with a fluorescent tag. After a period of incubation of 24 or 48 hours, positive cells display nuclear apple-green fluorescence under the microscope.
--The presence of cybomegalovirus can also be detected by histology in biopsy tissue or even in the cells present in body fluids (i.e. urine). The infected cells demonstrate an increased size (therefore named cytoMEGALOvirus) with a characteristic intranuclear, Homogenous, eosinophilic inclusion which occupies practically the entire nucleus of the cell. Smaller, dark intracytoplasmic inclusions may be also present, although in the absence of the intranuclear inclusions they are not diagnostic.
--In inconclusive cases, the sensitivity of the detection of the virus may be increased with the use of the peroxidase staining. This consists in the incubation of the tissue on a glass slide with antibodies to the virus. Positive cases show a strong, dark-brown or red staining (depending on the counterstain) in the nucleus of the cell. The cytoplasmic inclusions do not stain with this method. These stains (also known as immunostains) can be avaialable in 24 hours.
--The last diagnostic test for the detectio nof the virus is the measurement of the circulating antibodies (IgG) against the virus. Unfortunately, the ubiquitous presence of the virus and the common asymptomatic type infection makes the evaluation of a single measurement of antibody level difficult to interpret. A series of determinations demonstrating a rising of antibody titers is diagnostic.
--Newer "bed-side" tests based on the detection of IgM antibodies (present only in recent infections) are beginning to be available. Their accuracy, when compared with culture or histologic methods, is still being evaluated.
 |
Fig. 131 - CMV inclusion body
Hepatocyte with a large intranuclear inclusion body. Surrounded by a clear halo. Dark punctiform inclusions are seen also in the cytoplasm. H&E stain. |
 |
Fig. 132 - CMV neonatal hepatitis
Notice an area of necrosis with nuclear inclusions in hepatocytes and not much inflammatory reaction. H&E stain. |
HERPES SIMPLEX HEPATITIS
The agents are 2 enveloped DNA viruses: HIV1, HIV2. Type 1 produces herpes simplex infection especially recurrent blisters around the lips and generalized infections in older children and adults. Type 2 affects the genital tract and produces disseminated infection of the neonate with severe hepatic involvement. Disseminated herpes infection is commonly seen in immunocompromised patients (vesicular eruptions, encephalitis, esophagitis, keratitis). In the liver there are macroscopic yellow foci of necrosis and hemorrhage. Groups of hepatocytes surrounding these areas contain intranuclear eosinophilic viral bodies (Cowdry type A inclusions). Inflammatory response is minimal. Enlargement and multinucleation may precede the appearance of inclusion bodies. The infection is usually accompanied with disseminated intravascular coagulation. The virions can be demonstrated on biopsy material.
VARICELLA/ZOSTER HEPATITIS
The virus is similar to that of herpes simplex and CMV with intranuclear inclusions. It produces chicken pox in children and shingles in the adults. In debilitation, pregnancy, immunosuppression it may produce a disseminated disease which is usually fatal. The liver lesions are similar to those of herpes simplex, necrotizing with viral inclusions in hepatocytes.
EPSTEIN-BARR VIRUS--Infectious mononucleosis
This virus produces infectious mononucleosis in young adults throughout the world and seems to contribute to Burkitt's lymphoma and nasopharyngeal carcinoma. The infection in childhood is common and asymptomatic but it may rarely cause mononucleosis syndrome. In young adults the infection is very common and symptomatic. The difference is attributed to the exposure to a large quantity of viruses by deep kissing. The virus is a typical member of the Herpesviridae family: DNA core, a icosahedral capsid with 162 capsomers, a surrounding envelope, 120 nm in diameter. It is found in lymphoid tissues and in the epithelium of the nasopharynx and probably of the cervix. B lymphocytes acquire the virus mainly from the pharynx. After infection, the lymphocyte under the influence of the viral genome produce new antigens which are deposited on their surface. T lymphocytes react to these antigens, become blastoid and form the atypical lymphocytes of the peripheral blood seen in these patients who at this piont develop the full symptoms of infectious mononucleosis which, evidently, is immunopathologically mediated. Some individuals cannot mount this t-lymphocytic reaction will succumb to the primary EVB infection. This is the case of those suffering of X-linked lymphoprolipherative disorder, Duncan's syndrome.
Pathology
Mononucleosis hepatitis is characterized by peculiar necroinflammatory changes which, at the difference of classical viral hepatitides consist of more inflammation and less necrosis. There is marked mononuclear cell infiltration of sinusoids and portal fields contrasting with mild hepatocellular necrosis. The sinusoids are filled and distended with mononuclear cells which are large and sometimes clustered to resemble granulomas sometimes similar to sarcoidosis. The sinusoids are swollen adn the liver cell plates, in some areas, may be compressed and atrophic. Occasional Councilman bodies may be seen. Obviously, the sinusoidal infiltration reflects the mononucleosis picture of the peripheral blood.
Another peculiar feature is the presence of a marked regenerative activity of hepatocytes with presence of increased number of binucleate cells, polyploid nuclei and mitotic figures. This is probably the liver disease with the highest number of mitoses. Portal tracts are healvily infiltrated by mononuclear inflammatory cells but there is mild erosion of the limiting plates.
 |
Fig. 133 - Infectious mononucleosis hepatitis
Marked mononuclear cell infiltration of the sinusoids without significant necrosis. H&E stain. |
 |
Fig. 134 - Infectious mononucleosis heapatitis
High power of previous illustration showing the signs of high regenerative activity: binucleate cells and a mitotic figure. H&E stain. |
CONTENTS